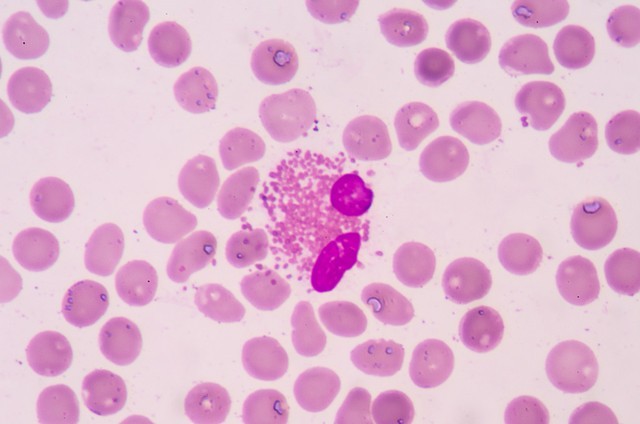

世界十大污染最严重排名第一 福岛核污染情况极其严重【二】
自 2011 连日本 3·11 大地震引发福岛核事故以来,福岛核污染问题持续引发关注。福岛第一核电站多次发生核泄漏事故,从 1979 年到 2011 年,共计出现 4 次事故,每次都有大量的核原料溢出,造成社会性的恐慌,连周边国家都被波及。

福岛核电站周边环境辐射值严重超标,比如日本排放核污水前几个小时,我国央视记者在福岛第一核电站周边 1.5 公里的位置检测,辐射值已达人体能承受辐射的 8 - 9 倍。
福岛核污染水的排放更是带来了严重影响。截至 2024 年 7 月 16 日,福岛第一核电站已进行了七轮核污染水排海。自 2023 年 8 月日本政府启动福岛第一核电站核污染水排海以来,已累计排放大量核污染水。核污染水排海导致日本水产品出口量以及部分水产品价格下滑,多地库存增加。福岛及周边地区的渔业、旅游业也深受影响,

福岛核污染还导致生物出现变异。比如天生没有耳朵的兔子、头部明显畸形且体长超常规的巨大狼鱼、九足章鱼、双头龟等。青少年患癌率增加 118 倍,甲状腺癌患者数量大幅增加。此外,福岛县东部沿海的浪江町等许多地方因为仍然存在高辐射风险,已经变成了无人区

。
福岛核污染对周边生物的长期影响
自日本福岛核事故发生以来,周边生物长期受到严重影响。福岛地区出现了众多生物变异的现象,如天生没有耳朵的兔子、头部明显畸形且体长超常规的巨大狼鱼、九足章鱼、双头龟等。青少年患癌率增加 118 倍,甲状腺癌患者数量大幅增加。海洋生物也未能幸免,韩国石斑鱼大量死亡,且对其生存环境造成巨大破坏。日本动物专栏记者佐藤荣记拍摄的纪录片显示,自 2014 年左右开始,缺少眼睛、翅膀,无法羽化直接死去的动物增多。40 只羽化的蜻蜓中就有 3 只无法飞翔,比例相当高。美国生物学家蒂莫西·慕梭指出,即使处理过的核污染水,也会携带无法消除的“氚”等放射性元素,这会对地球食物链造成长期影响。核污染导致海洋生态系统受损,影响海洋生物的繁衍和生存,部分物种可能受到辐射而死亡,破坏了生态平衡。

福岛核污染对人体健康的具体危害
核辐射对人体的危害极大。急性放射病在一次或短时间内受到大剂量电离辐射可能会造成,病情严重程度与辐射剂量有关,会造成骨髓造血组织损伤,白细胞减少等,严重者有可能导致死亡。慢性放射病在较长时间内连续或间断受到较高辐射,累积到一定剂量后可能导致,特点是起病慢,病程长,症状多。长期接触电离辐射及放射性核素可增加肿瘤风险,放射工作者发生白血病和皮肤癌的概率增高,接触放射性物质的矿工易患肺癌,原子弹爆炸和核辐射造成白血病的发病率增高。

此外,如长期受到超标核辐射影响,会损伤中枢神经系统,人可能出现头晕、头痛、多梦、失眠、记忆力衰退和心悸等症状。会引发心血管疾病,如心动过速、心律不齐、低血压等。会造成血液系统疾病,核辐射可能导致多核白细胞、嗜中粒细胞、网状白细胞增多而淋巴细胞减少。会使生殖系统受损,辐射可使男性性功能下降,女性月经失调、闭经等,也是孕妇早产、流产、不育、畸胎等诱发因素。较高剂量下,核辐射会破坏人体 DNA,新的白细胞无法正常生成,人体免疫系统很快就会崩溃,各种感染随之而来。
福岛核污染在全球范围内的扩散范围
福岛核污染已经扩散至两大洋。日本筑波大学研究人员日前发布研究成果称,2011 年福岛核电站事故中流入海洋的放射性物质铯 137 抵达美国西海岸后部分北上,经太平洋最北部的白令海,约 7 至 8 年后回流至日本东北沿岸。同时,在北冰洋也检测到源自福岛核事故的铯 137。韩国海洋科学技术院、核能研究院公布科研成果称,福岛核污水排海后,受洋流影响,很可能 2 年左右就会暂时流入济州海域,而 10 年后将扩散至整个北太平洋海域。韩国研究结果认为,核污水排入海洋后,氚元素约在 10 年后扩散至北太平洋各处海域。

福岛核污染对当地经济的持续冲击
福岛核电站事故对当地经济造成了多方面的持续冲击。首先,周边地区成为无人居住区域,这对当地的农业、渔业和旅游业造成了严重打击。农作物和海产品受到核污染,销售和出口遭到严重限制,旅游景点也因核污染而无法运营,导致地方经济的衰退和失业的增加。其次,福岛核电站事故引发了大规模的撤离和重新安置需求,数万人被迫离开核灾后区域,他们失去了家园和工作。

福岛核电站事故对日本电力供应造成了严重的冲击,导致多个核电机组停止运行,电力供应出现短缺。为了弥补能源缺口,日本不得不大量进口油气和煤炭,这导致能源进口成本大幅上升,能源开支的增加使得经济受到了重大压力。福岛核电站事故还对日本工业产业链造成了连锁反应,部分企业停工或者转移到其他地区,产能受到限制,对相关供应链和就业市场产生了冲击。最后,福岛核电站事故对日本的国际声誉造成了重大影响,国际上对日本核能的信任度下降,一些国家限制了与日本的核能合作和贸易,对日本的出口和国际合作带来了阻碍。

综上所述,福岛核污染的情况极其严重,对周边生物、人体健康、全球环境、当地经济等多个方面都造成了巨大且长期的负面影响。治理福岛核污染是一项艰巨且漫长的任务,需要国际社会共同关注和努力。